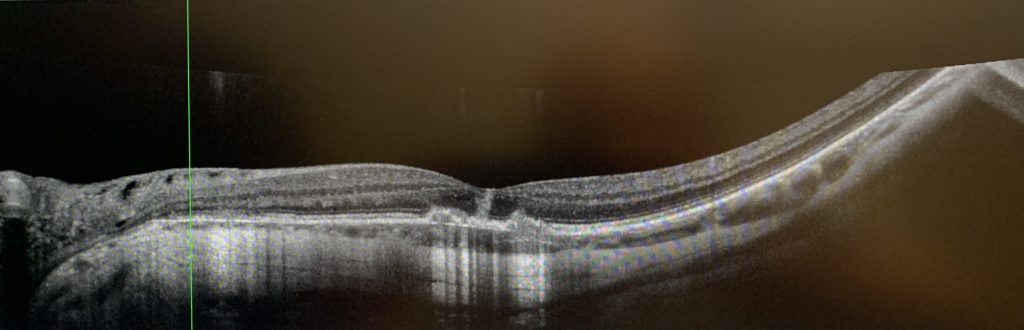

Visual Changes Call for Action
On the afternoon of June 6, 2024, I took out my phone as usual, preparing to make a call. However, when I looked at the screen, I noticed a very subtle indentation above the keyboard numbers, which immediately raised my concern. Consequently, I quickly called a retinal specialist’s office to schedule an appointment. Why was I so sensitive to the change in the appearance of the phone’s keypad? This can be traced back to an experience from several years ago.
One evening in October 2017, while making a call, I casually glanced at the screen with my right eye and noticed a slight imperfection above the keyboard numbers, but I did not pay it much attention at the time. It wasn’t until the issue worsened and I began to see dark spots in my vision that I recognized the seriousness of the situation, prompting me to visit an ophthalmologist. After an examination, the doctor referred me to a retinal specialist. At the specialist’s clinic, following dilation and a thorough examination of my retina, I was diagnosed with macular degeneration in my right eye.
The wet form of macular degeneration typically arises from the abnormal growth of blood vessels in the macular region of the retina, leading to the leakage of fluid or blood into this area. The macula, located at the center of the retina, is crucial for providing sharp central vision. Any damage to this area can result in a decline in central vision and visual distortions. Those affected may experience difficulties in reading, challenges in recognizing faces, noticeable blurred spots or blind spots in their field of vision, and in severe cases, it can lead to blindness, making it one of the most prevalent causes of vision loss in ophthalmology.
After diagnosis, my doctor administered intravitreal injections of anti-vascular endothelial growth factor (anti-VEGF) in my right eye. However, the condition continued to worsen, resulting in multiple episodes of bleeding and the emergence of severe symptoms associated with macular degeneration. Although ongoing treatment provided some relief, my right eye’s vision suffered damage. Fortunately, my left eye remained unaffected by any bleeding, maintaining a normal vision level of 20/20. Since then, my left eye has primarily taken on the responsibility of my visual function.
Due to my previous experience with my right eye, I approached this visit with great caution and went to the retinal specialty clinic the following day as scheduled. After the examination, the doctor confirmed that my left eye’s vision was normal, but I had a posterior vitreous detachment. The vitreous is the gel-like substance that fills the space between the lens and the retina in the eye, and its liquefaction can lead to separation from the inner surface of the retina, a condition that is more common in older adults. Typically, if there are no vision-threatening complications, this condition will resolve on its own within about a month. Therefore, the doctor advised me to return home and continue monitoring the situation. After further evaluation, the possibility of macular disease was ruled out, which finally eased my concerns, allowing me to return to my normal life and work.
Rapid Deterioration of Condition
On the sixth day following my consultation, my condition unexpectedly worsened. While examining the keys on my phone screen, I noticed that the area of indentation above the numbers seemed to have increased. When using my left eye to view objects, I experienced dullness in color perception. By evening, my symptoms had not only failed to improve but had intensified, prompting me to call the emergency line for my retinal specialist. After thoroughly assessing my situation, the doctor scheduled me for the first appointment the following morning.
On that morning, I visited the clinic for an examination, where it was determined that my left eye’s vision had declined from 20/20 to 20/25. Although no bleeding was observed in the retina, due to my history of macular disease, the doctor could not rule out the possibility of undetected abnormal vascular edema. Consequently, it was decided to administer an intravitreal injection of anti-VEGF for my left eye to facilitate timely treatment should macular disease arise. The doctor also advised me to monitor my condition at home and to contact the clinic if I experienced any discomfort.
The day after the treatment, my symptoms continued to worsen, with my left eye’s vision becoming increasingly blurred and a shadow appearing in the upper left portion of my visual field. Although the Amsler grid test did not reveal any distortion, the black dot in the center of the grid would disappear when I moved my eye. During a follow-up examination at the clinic, my left eye’s vision had deteriorated further to 20/50. After reviewing the latest results from various specialized ocular tests and consulting with three retinal specialists in the clinic, I was ultimately diagnosed with uveitis.
The uvea refers to the middle layer of the eye, which includes the iris, ciliary body, and choroid, and is rich in blood vessels and pigment, serving multiple functions within the eye. Inflammation in this area can rapidly damage the eye, leading to long-term complications. Among ocular diseases that can result in blindness, uveitis ranks fifth. Due to the variety of types and complex causes of this condition, diagnosis can be particularly challenging, especially in the early stages of certain types. Given the condition of my right eye, and to ensure that my left eye receives optimal treatment, the clinic’s doctor decided to refer me to the respected retinal disease expert, Dr. K. Bailey Freund, a clinical professor of ophthalmology at NYU Grossman School of Medicine.

A Precise Diagnosis and Treatment Plan
On my way to Dr. Freund’s clinic, I noticed that the vision in my left eye was becoming increasingly blurred, as if a veil had been placed over it, making it difficult to read the letters on the nearby “STOP” sign. During the subsequent examination, my left eye’s vision had deteriorated to 20/100, prompting the clinic to conduct a more comprehensive specialist assessment. When Dr. Freund entered the examination room, I noted that he appeared to be in his sixties, with graying hair and a full white beard. He carefully inquired about the progression of my eye condition, thoroughly analyzed the results of all the ocular examinations, and took into account my previous medical history.
Upon learning of my diagnosis of rheumatoid arthritis, Dr. Freund requested a detailed account of my condition. This all began around seventeen or eighteen years ago when I experienced pain and stiffness in multiple joints throughout my body. Following a detailed assessment and laboratory evaluations, a specialist validated my diagnosis of rheumatoid arthritis and implemented an extensive treatment strategy that successfully controlled my symptoms. For the past three years, I have not experienced any flare-ups.
Why is Dr. Freund concerned about my rheumatoid arthritis? Because the underlying mechanisms of uveitis are quite complex and may stem from infections, trauma, autoimmune responses, or other inflammatory diseases. Each of these causes necessitates a distinct treatment approach. Rheumatoid arthritis arises from a dysfunction in the immune system, which not only damages the joints but can also affect other organs, such as the brain, heart, and even the eyes. Therefore, uveitis may be associated with this condition.
After a comprehensive evaluation, Dr. Freund diagnosed my eye condition as punctate inner choroiditis, a rare form of multifocal chorioretinal inflammatory disease that can result in choroidal neovascularization. In light of my prior severe macular degeneration, this condition may significantly jeopardize my visual prognosis. Given the rapid progression of the condition, immediate treatment was necessary. Dr. Freund promptly prescribed an emergency medication plan and arranged for relevant laboratory tests, while also inviting a rheumatologist to participate in the consultation and join the treatment team
Relieving Intraocular Inflammation and Regaining Clarity
Upon learning about my eye condition, I inevitably felt a sense of anxiety. The fear associated with this diagnosis was unprecedented compared to the various illnesses I had previously experienced. Given that my right eye had sustained an injury, the possibility of ineffective treatment for my left eye raised the alarming prospect of losing my vision, casting a shadow over my future. However, Dr. Freund’s calm demeanor and confidence greatly inspired me, bolstering my resolve to combat the illness.
The medications prescribed by my doctors included corticosteroid, immunosuppressants, and biologics. After starting these treatments, I noticed that the veil obscuring my left eye began to lift, with dark spots gradually diminishing or even disappearing. My vision became clearer, and the areas of blurriness continued to decrease, ultimately focusing on the center of my field of vision. My left eye’s sight steadily improved, progressing from 20/50 in the second week to 20/40, 20/30, and finally 20/25, maintaining this positive state until September. However, an unexpected incident disrupted this recovery process, leading to a setback.
To minimize side effects, certain medications require a gradual reduction or cessation at various stages of treatment, which can often lead to rebound effects. Around mid to late September, after more than three months of corticosteroid reduction, I suddenly noticed an obvious worsening of my left eye’s vision, with increased blurriness and dimness. I promptly visited Dr. Freund’s clinic, where it was determined that my left eye’s vision had dropped to 20/40, and new inflammatory lesions were present. The doctors immediately adjusted my medication dosage. Fortunately, under the doctor’s guidance, the adjustments to my medication proved effective, stabilizing the treatment and gradually alleviating my symptoms, including the long-standing central blurriness in my left eye.
As I returned to the clinic for follow-up visits, I gradually developed a good rapport with the staff. They expressed joy at my improvement, with Dr. Freund referring to it as “very fortunate,” while the rheumatologist considered it a “miracle.” However, I am acutely aware that without their exceptional medical skills and teamwork, no amount of luck or miracles could have manifested in my case. I am deeply moved by their efforts in restoring my vision, which has allowed the previously missing digits on my phone screen to gradually reappear, ultimately filling in completely. My left eye’s vision has now returned to its pre-illness state.
As this year comes to a close, my grandson has entered the world. When I clearly see his delicate features, a wave of warmth fills my heart, and I am profoundly grateful to the medical team that dedicated themselves to treating my eye condition. I wish to express my appreciation for them through the written word, holding the pen in my regained sight. My treatment is still ongoing, and due to the high risk of recurrence associated with this condition, I must continue to face the challenges of prevention and management. Maintaining a regular lifestyle, ensuring adequate sleep, engaging in moderate exercise, keeping a balanced diet, avoiding excessive fatigue, and closely collaborating with my doctors are the effective measures I can take.
This experience has profoundly highlighted the immeasurable impact of vision loss on quality of life. To ensure a high quality of living, we must prioritize eye health, adhere to medical advice, and pay attention to the small details of daily life. If any vision abnormalities are detected, it is imperative to act promptly.